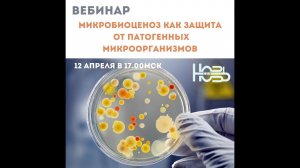
Микробиоценоз как защита от патогенных микроорганизмов

50:36
50:36
2022-04-13 10:01

 25:37
25:37

 25:37
25:37
2025-09-18 19:55

 9:21
9:21

 9:21
9:21
2025-09-19 12:01

 11:55
11:55

 11:55
11:55
2025-06-24 16:08

 28:41
28:41

 28:41
28:41
2025-09-18 18:56

 10:08
10:08

 10:08
10:08
2025-09-19 02:30

 44:26
44:26

 44:26
44:26
2025-09-18 18:10

 4:55
4:55

 4:55
4:55
2025-09-18 22:28

 13:43
13:43

 13:43
13:43
2025-09-19 03:36

 36:43
36:43

 36:43
36:43
2025-09-19 17:12

 5:23
5:23

 5:23
5:23
2025-09-19 13:00

 2:16
2:16

 2:16
2:16
2022-10-06 07:41

 1:05:46
1:05:46

 1:05:46
1:05:46
2021-06-08 07:11

 3:28
3:28

 3:28
3:28
2025-09-19 11:00

 8:05
8:05

 8:05
8:05
2025-09-18 15:53

 2:18
2:18

 2:18
2:18
2025-09-06 12:50

 40:23
40:23

 40:23
40:23
2025-09-18 18:00

 5:22
5:22
![Абдуллах Борлаков, Мекка Борлакова - Звездная ночь (Премьера клипа 2025)]() 4:25
4:25
![Roza Zərgərli, Мурад Байкаев - Неизбежная любовь (Премьера клипа 2025)]() 2:34
2:34
![Tamo ft Djan Edmonte - Ну что красавица (Премьера клипа 2025)]() 3:10
3:10
![Руслан Шанов - Особенная (Премьера клипа 2025)]() 2:16
2:16
![Alex Lim, Игорь Крутой - Вокзал (Премьера клипа 2025)]() 3:32
3:32
![BITTUEV - Не плачь (Премьера клипа 2025)]() 2:18
2:18
![Enrasta - За тобой (Премьера клипа 2025)]() 2:41
2:41
![Григорий Герасимов - Сгоревшие мосты (Премьера клипа 2025)]() 3:05
3:05
![Игорь Балан - Белая зима (Премьера 2025)]() 3:10
3:10
![Анжелика Агурбаш - Утро (Премьера клипа 2025)]() 3:33
3:33
![Равшанбек Балтаев - Кастюм (Премьера клипа 2025)]() 3:59
3:59
![Мухит Бобоев - Маликам (Премьера клипа 2025)]() 3:18
3:18
![Жамхур Хайруллаев - Битта дона (Премьера клипа 2025)]() 2:49
2:49
![Magas - Только ты (Премьера клипа 2025)]() 3:04
3:04
![Руслан Добрый - Тёплые края (Премьера клипа 2025)]() 2:14
2:14
![Бриджит - Ласковый май (Премьера клипа 2025)]() 3:20
3:20
![NIKA DUBIK, Winter Spirit - Искры (Премьера клипа 2025)]() 4:27
4:27
![Наталья Влади - Я обещаю (Премьера клипа 2025)]() 3:00
3:00
![Gulinur - Nishatar (Official Video 2025)]() 3:40
3:40
![Слава - В сердце бьёт молния (Премьера клипа 2025)]() 3:30
3:30
![Гедда | Hedda (2025)]() 1:48:23
1:48:23
![Только ты | All of You (2025)]() 1:38:22
1:38:22
![Трон: Арес | Tron: Ares (2025)]() 1:52:27
1:52:27
![Большое смелое красивое путешествие | A Big Bold Beautiful Journey (2025)]() 1:49:20
1:49:20
![Баллада о маленьком игроке | Ballad of a Small Player (2025)]() 1:42:60
1:42:60
![Порочный круг | Vicious (2025)]() 1:42:30
1:42:30
![Мужчина у меня в подвале | The Man in My Basement (2025)]() 1:54:48
1:54:48
![Свинтусы | The Twits (2025)]() 1:42:50
1:42:50
![Карты, деньги, два ствола | Lock, Stock and Two Smoking Barrels (1998) (Гоблин)]() 1:47:27
1:47:27
![Большой Лебовски | The Big Lebowski (1998) (Гоблин)]() 1:56:59
1:56:59
![Дом из динамита | A House of Dynamite (2025)]() 1:55:08
1:55:08
![Орудия | Weapons (2025)]() 2:08:34
2:08:34
![Фантастическая четвёрка: Первые шаги | The Fantastic Four: First Steps (2025)]() 1:54:40
1:54:40
![Стив | Steve (2025)]() 1:33:34
1:33:34
![Школьный автобус | The Lost Bus (2025)]() 2:09:55
2:09:55
![Французский любовник | French Lover (2025)]() 2:02:20
2:02:20
![Криминальное чтиво | Pulp Fiction (1994) (Гоблин)]() 2:32:48
2:32:48
![Диспетчер | Relay (2025)]() 1:51:56
1:51:56
![Рок-н-рольщик | RocknRolla (2008) (Гоблин)]() 1:54:23
1:54:23
![Властелин колец: Возвращение бомжа | The Lord of the Rings: The Return of the King (2003) (Гоблин)]() 3:21:07
3:21:07
![Рэй и пожарный патруль Сезон 1]() 13:27
13:27
![Монсики]() 6:30
6:30
![Мультфильмы военных лет | Специальный проект к 80-летию Победы]() 7:20
7:20
![Роботы-пожарные]() 12:31
12:31
![Крутиксы]() 11:00
11:00
![Отважные мишки]() 13:00
13:00
![Последний книжный магазин]() 11:20
11:20
![Новое ПРОСТОКВАШИНО]() 6:30
6:30
![Чемпионы]() 7:35
7:35
![Простоквашино. Финансовая грамотность]() 3:27
3:27
![Школьный автобус Гордон]() 12:34
12:34
![Папа Супергерой Сезон 1]() 4:28
4:28
![Мотофайтеры]() 13:10
13:10
![Игрушечный полицейский Сезон 1]() 7:19
7:19
![Корги по имени Моко. Защитники планеты]() 4:33
4:33
![Тёплая анимация | Новая авторская анимация Союзмультфильма]() 10:21
10:21
![Ну, погоди! Каникулы]() 7:09
7:09
![Врумиз. 1 сезон]() 13:10
13:10
![Псэмми. Пять детей и волшебство Сезон 1]() 12:17
12:17
![Пип и Альба. Приключения в Соленой Бухте! Сезон 1]() 11:02
11:02

 5:22
5:22Скачать видео
| 256x144 | ||
| 640x360 | ||
| 1280x720 |
 4:25
4:25
2025-11-07 13:49
 2:34
2:34
2025-11-05 11:45
 3:10
3:10
2025-11-07 13:57
 2:16
2:16
2025-10-31 12:47
 3:32
3:32
2025-10-31 15:50
 2:18
2:18
2025-10-31 15:53
 2:41
2:41
2025-11-07 14:04
 3:05
3:05
2025-11-06 12:13
 3:10
3:10
2025-11-07 14:48
 3:33
3:33
2025-11-02 10:06
 3:59
3:59
2025-11-04 18:03
 3:18
3:18
2025-11-02 10:30
 2:49
2:49
2025-11-06 13:20
 3:04
3:04
2025-11-05 00:49
 2:14
2:14
2025-11-05 00:29
 3:20
3:20
2025-11-07 13:34
 4:27
4:27
2025-10-31 16:00
 3:00
3:00
2025-11-03 12:33
 3:40
3:40
2025-10-31 13:38
 3:30
3:30
2025-11-02 09:52
0/0
 1:48:23
1:48:23
2025-11-05 19:47
 1:38:22
1:38:22
2025-10-01 12:16
 1:52:27
1:52:27
2025-11-06 18:12
 1:49:20
1:49:20
2025-10-21 22:50
 1:42:60
1:42:60
2025-10-31 10:53
 1:42:30
1:42:30
2025-10-14 20:27
 1:54:48
1:54:48
2025-10-01 15:17
 1:42:50
1:42:50
2025-10-21 16:19
 1:47:27
1:47:27
2025-09-23 22:52
 1:56:59
1:56:59
2025-09-23 22:53
 1:55:08
1:55:08
2025-10-29 16:30
 2:08:34
2:08:34
2025-09-24 22:05
 1:54:40
1:54:40
2025-09-24 11:35
 1:33:34
1:33:34
2025-10-08 12:27
 2:09:55
2:09:55
2025-10-05 00:32
 2:02:20
2:02:20
2025-10-01 12:06
 2:32:48
2:32:48
2025-09-23 22:52
 1:51:56
1:51:56
2025-09-24 11:35
 1:54:23
1:54:23
2025-09-23 22:53
 3:21:07
3:21:07
2025-09-23 22:52
0/0
2021-09-22 23:51
 6:30
6:30
2022-03-29 19:16
 7:20
7:20
2025-05-03 12:34
2021-09-23 00:12
 11:00
11:00
2022-07-25 18:59
 13:00
13:00
2024-11-29 13:39
 11:20
11:20
2025-09-12 10:05
 6:30
6:30
2018-04-03 10:35
 7:35
7:35
2025-11-01 09:00
 3:27
3:27
2024-12-07 11:00
 12:34
12:34
2024-12-02 14:42
2021-09-22 21:52
 13:10
13:10
2024-11-27 14:57
2021-09-22 21:03
 4:33
4:33
2024-12-17 16:56
 10:21
10:21
2025-09-11 10:05
 7:09
7:09
2025-08-19 17:20
2021-09-24 16:00
2021-09-22 22:23
2021-09-22 23:36
0/0

